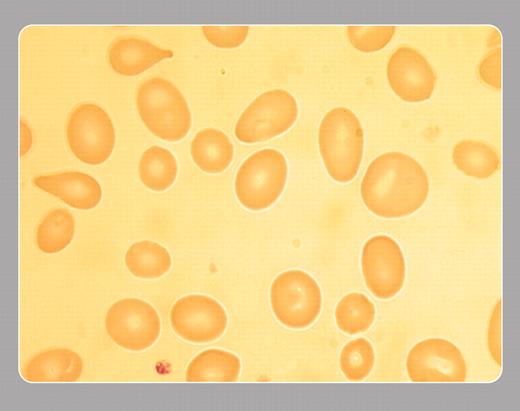
graphic

Note the macro-ovalocytes with tailed forms characteristic of vitamin B12 or folate deficiency states.
THE ASH IMAGE BANK, a reference and teaching tool, is continually updated with new atlas images and images of case studies. For more information or to contribute to the Image Bank, visitwww.ashimagebank.org.
Copyright © 2003 The American Society of Hematology
2003